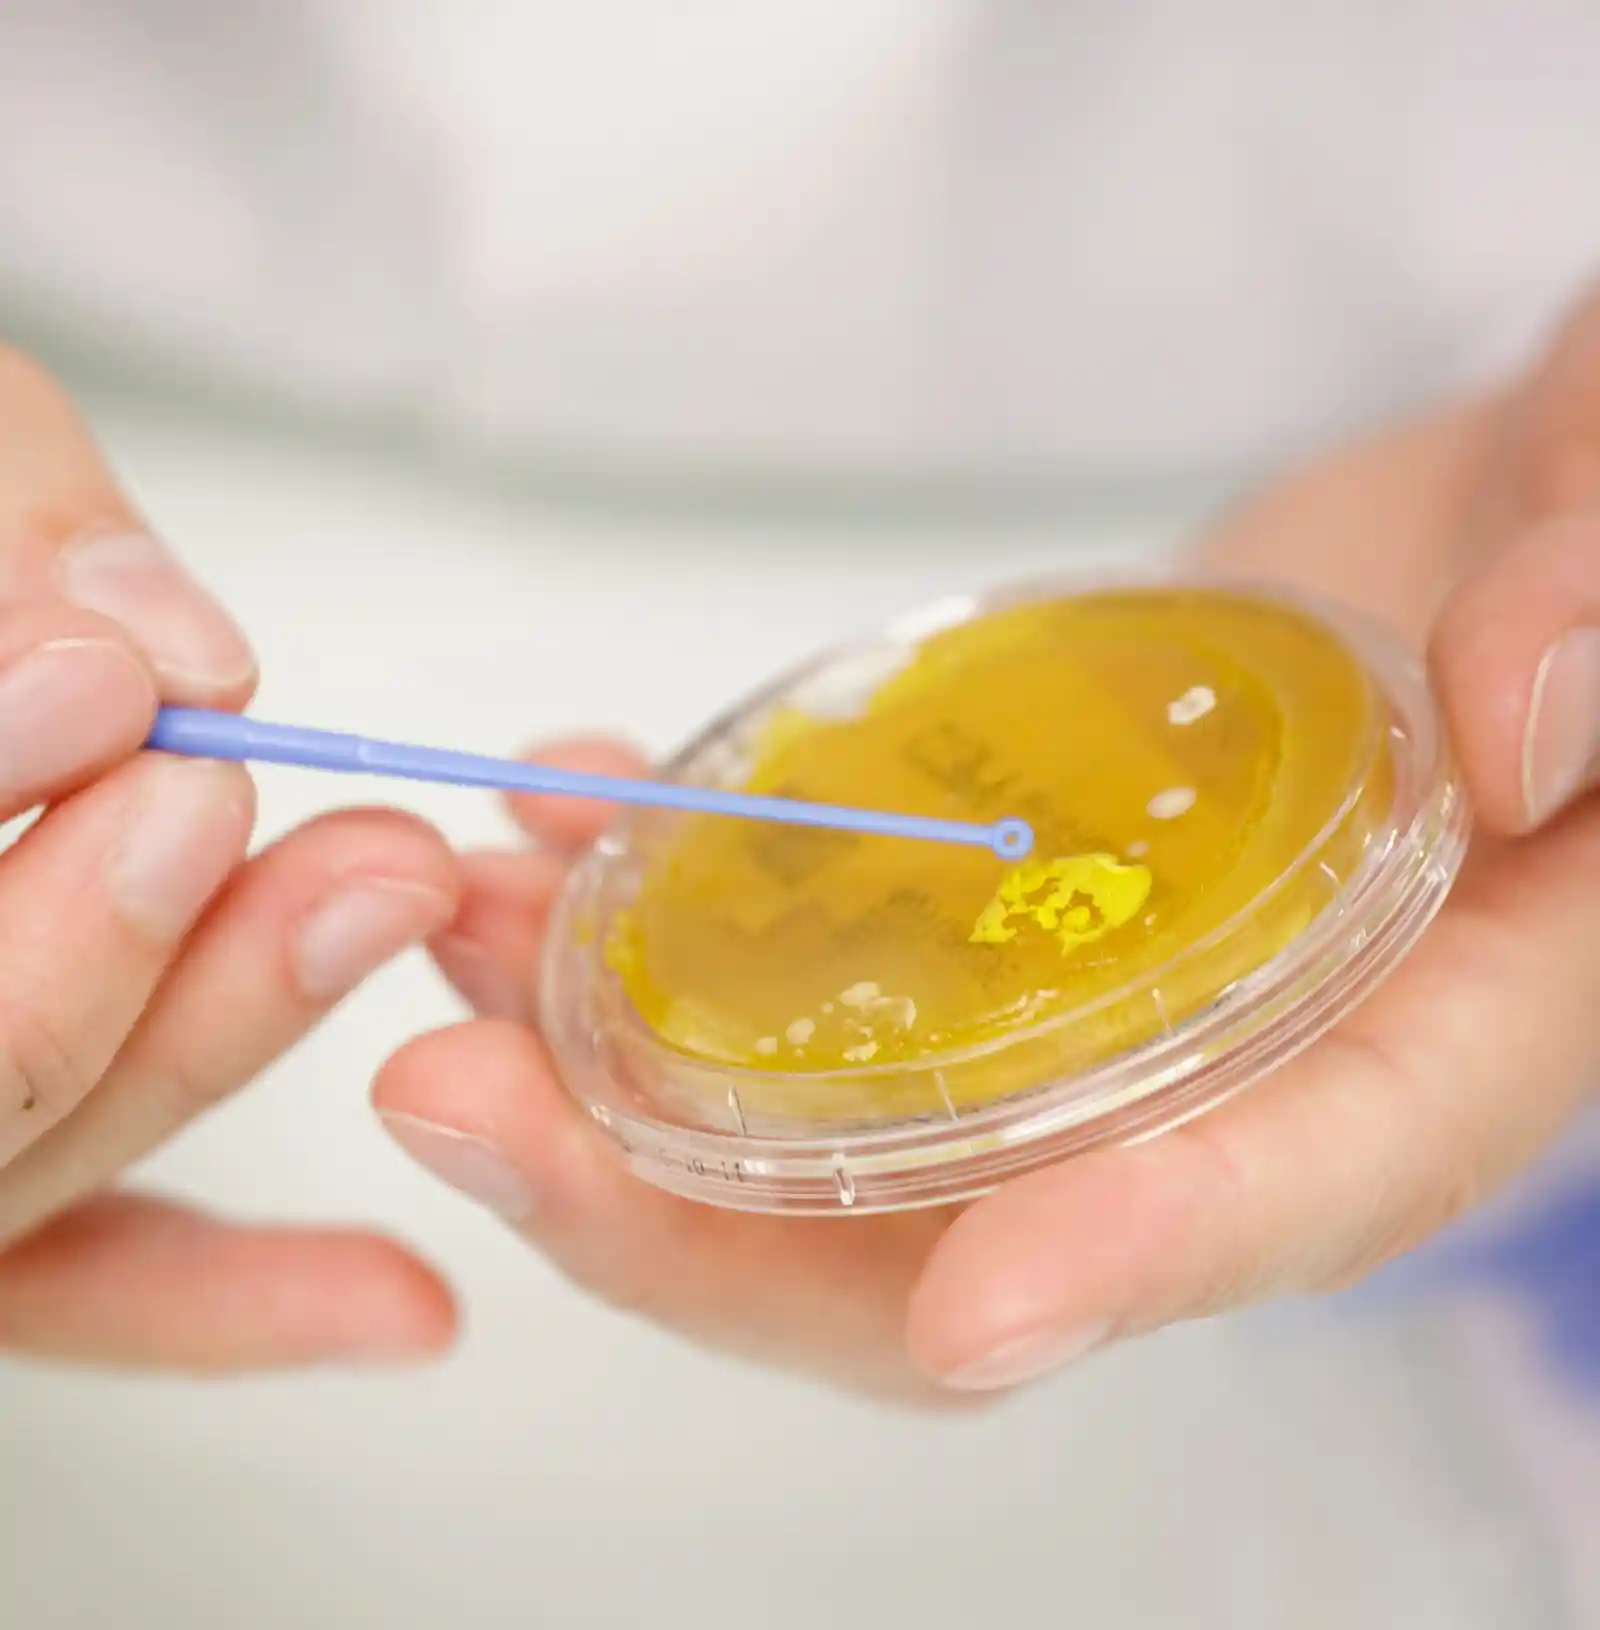

Your
Expert Partner
for health product
safety
Leader in safety for Medical Device in France

Présentation
Le Groupe Icare
With 30 years expérience, the Groupe ICARE stands out as a leader European CRO* in international standardisation and regulation. We guide healthcare industry through the complex regulatory landscape, ensuring that every device and products is marketed in full compliance and safety.
Our expertise covers a wide range of services critical to deliver the excellence and compliance of your products:
- Biocompatibility & Toxicology: Rigorous assessment for safe use.
- Validation & Qualification : Certified processes for proven performance.
- Microbiology & Contamination Control: Strict protocols for flawless microbiological integrity.
- Quality & Regulatory Affairs: Constant monitoring for uncompromising compliance.
- Training & Consulting : Shared expertise for perfect control.
Key figues
1
international group
4
sites
2 sites in France - 1 site in Suisse - 1 site in Brésil
1 800
clients in 40 countries
5 000 sp.m
of which 3 500 sq.m of clean rooms
Over 220
employees